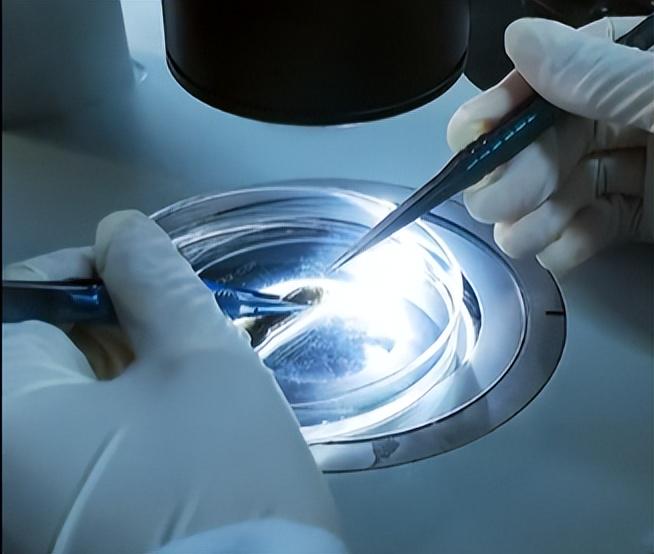

作品声明:个人观点、仅供参考
各位看官老爷,麻烦右上角点击一下“关注”,精彩内容不错过,方便随时查看。
文|万象硬核
编辑|万象硬核
«——【·前言·】——»
2022年9月,中国海洋大学教授孙进坐在科考船上,他看着无人遥控潜水器传回的实时画面,好像在找啥一样。
很快潜水器就来到了1385米深的地方,于是按照指令,它挖了一些深海的底泥出来当样本。

突然,几条白色生物出现在时事传回来的画面上,这模样让孙进觉得不大一般。
于是他操纵着无人遥控潜水器将这些生物一起带了回来。
很快无人遥控潜水器就带着样本回到了船上,孙进拿起采集回来的样本,结果发现里面竟然有20多条。

孙进有些懵圈,因为他发现自己之前好像从没见到过这些生物,它们的体表没有常见贝类的外壳,却覆盖着细密的角质层和细小钙刺,触感粗糙如毛皮。
他反复端详着这些“陌生来客”,脑海中快速检索着所有已知的海洋生物类别,却始终找不到匹配的答案。

此时的孙进尚大概想不到,这次看似偶然的发现,即将填补中国尾腔动物研究的空白,更会为深海生物学研究开辟全新维度。
10月份,科考船载着这20多条神秘生物返回青岛,孙进叫来自己的学生开始研究。

他们把类似的资料前前后后都翻了一遍,然后一个个进行排除,最后发现这种生物好像之前从没有人记载过。
孙进瞬间就惊喜起来,他想着这可能是一种新物种!
于是根据形态特征,孙进团队初步将目标锁定在软体动物门下的尾腔动物纲。

这类生物又称毛皮贝,是软体动物中较为特殊的类群,它们摒弃了常见贝类的外壳,演化出蠕虫状的躯体,体表覆盖的角质层和钙刺成为其标志性特征。
但要确认新物种身份,必须找到决定性的分类依据,也就是说要把它的形态特征要搞清楚。

毛皮贝的分类特征主要包括齿舌、体表钙刺形状、体型和口盾形状,其中齿舌是最关键的依据。
而他们很快发现,这个新物种的齿舌几乎“隐藏”得无迹可寻。
常规尾腔动物的齿舌本就十分微小,而这种毛皮贝的齿舌更是高度退化,仅有约190微米,相当于两根头发丝的直径总和。

更棘手的是,他们就抓了20多条,经过几次初步解剖尝试失败后,团队成员都不敢动手了。
但孙进还是说,这些生物的数量估计不少,就是生存的环境比较恶劣而已,所以团队成员都开始动手了。
于是在2023年9月的一个深夜,团队成员将又一个处理后的样品放到体视镜下时,视野中突然出现了两个细小的白色结构:正是他们寻觅已久的齿舌!

孙进立刻凑到镜前,确认这对连接在中心柱上的齿舌,正属于尾腔动物中物种最多的科。
后来他们拍下了清晰的照片,也逐步揭开了这种新物种的生活习性之谜。
因为它状似“游龙”身披“鳞甲”,所以团队成员给它起了一个名字叫做神龙毛皮贝。

«——【·珍贵的“神龙”·】——»
神龙毛皮贝的家园位于1385米深的海马冷泉沉积物下数十公分处,这里是常人难以想象的极端环境:
终年黑暗无光,海水压力相当于138个标准大气压,温度常年维持在 4℃左右,且充斥着甲烷、硫化氢等有毒气体。

这样的环境对大多数生物而言是生命禁区,但对神龙毛皮贝来说,却是绝佳的藏身之所。
尾腔动物多是典型的底内动物,喜欢深埋在底质中,神龙毛皮贝更是将这种习性发挥到了极致。
神龙毛皮贝体长可达15厘米,远超一般尾腔动物不超过5厘米的体型。

蠕虫状的躯体让它们能在沉积物中灵活穿梭,体表覆盖的角质层起到了隔绝有毒物质的保护作用,而细小的钙刺则如同“鳞甲”般增强了躯体强度。
团队通过细致观察发现,这些钙刺的分布还暗藏玄机:越靠近尾部,钙刺长度越长,且在躯体前中段存在独特的等腰三角形钙刺,这种结构差异可能与运动发力和挖掘功能密切相关。

其口部位于口盾中央,被口盾完全包围,这种结构能在进食时过滤掉沉积物中的杂质。
而那对高度退化的齿舌,虽失去了常规贝类的咀嚼功能,却仍保留着分类学价值:其中心柱钙化程度极低,几近透明,成为确认新物种的关键依据。

作为中国首个被报道的尾腔动物,神龙毛皮贝最令人震惊的习性是其在化能合成生态系统中的生存能力。
此前科学界普遍认为,尾腔动物多以浅海沉积物中的硅藻、有孔虫等为食,而神龙毛皮贝却能在缺乏阳光的深海冷泉中繁衍生息,这背后离不开冷泉生态系统特有的“能量循环”。

海马冷泉区域活跃的流体活动不断释放甲烷等化学物质,而化能合成微生物能利用这些化学能将无机物转化为有机物,形成独特的“化能合成食物链”。
孙进团队通过基因检测和肠道内容物分析推测,神龙毛皮贝可能通过摄食沉积物中的化能合成微生物及其代谢产物生存,其肠道菌群也可能参与了有毒物质的降解过程。

这一发现彻底改写了尾腔动物的生态位认知。
“它是第一个被报道生活在化能合成生态系统的尾腔动物,也是首次被发现与深海冷泉有关的无板类。”
这种特殊的食性适应,不仅展现了生命的顽强与多样,更揭示了深海生态系统中未被发现的物质循环路径。

如今,神龙毛皮贝的模式标本被珍藏在中国海洋大学海洋生物博物馆。
孙进团队并未停下探索的脚步,他们正在整理第二次科考采集的样品,希望能发现更多神龙毛皮贝的生态秘密,同时针对其耐极端环境的基因机制展开深入研究。

它不仅让我们读懂了生命的坚韧与多样,更提醒着我们:在征服深海的道路上,敬畏自然、尊重科学,才是发现更多奥秘的钥匙。
参考:
青岛宣传网《青岛故事|深海“寻龙”记:他们发现新物种“神龙”,在深蓝世界书写中国科研答卷!》2025-11-6
青岛晚报《【青岛晚报】海大教授深海“寻龙记”》2025-3-22























热门跟贴